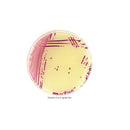
Chromatic GBS

Descrizione
Terreno cromogenico utilizzato per l’isolamento e la differenzia- zione di Streptococcus agalactiae da campioni clinici come secre- zione vaginale, urine, fluido gastrico.
20 pz (90mm)
Codice: 11639
Pagamenti sicuri con
Le tue informazioni di pagamento sono trattate in sicurezza. I dettagli della tua carta non verranno conservati.